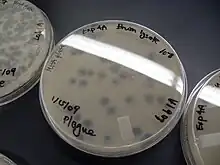

Mycobacterium smegmatis
| Domaine | Bacteria |
|---|---|
| Embranchement | Actinomycetota |
| Classe | Actinomycetes |
| Ordre | Mycobacteriales |
| Famille | Mycobacteriaceae |
| Genre | Mycobacterium |
Espèce
(Trevisan 1889) Lehmann & Neumann 1899
Mycobacterium smegmatis est une espèce bactérienne acido-résistante du phylum Actinobacteria et du genre Mycobacterium. Ce microbe est long de 3 à 5 μm et présente une forme de bacille ; il peut être coloré par la méthode Ziehl-Neelsen et la méthode fluorescente auramine-rhodamine. Il a été signalé pour la première fois en novembre 1884 par Lustgarten, qui a trouvé un bacille avec la coloration apparente de bacilles tuberculeux dans les chancres syphilitiques. Par la suite, Alvarez et Tavel ont trouvé des organismes similaires à ceux décrits par Lustgarten également dans les sécrétions génitales normales (smegma). Cet organisme a été nommé plus tard M. smegmatis[1].
Virulence
M. smegmatis est généralement considéré comme un micro-organisme non pathogène ; cependant, dans certains cas très rares, il peut provoquer une maladie[2].
Utilisation en recherche
M. smegmatis est utile pour l'analyse de recherche d'autres espèces de Mycobactéria dans des expériences de laboratoire. M. smegmatis est couramment utilisé dans les travaux sur le genre Mycobacterium car il est du type « croissance rapide » et non pathogène. M. smegmatis est un modèle simple, facile à travailler, c'est-à-dire avec un temps de doublement rapide et ne nécessite qu'un laboratoire de niveau de biosécurité 1. Le temps et les infrastructures lourdes nécessaires pour travailler avec des espèces pathogènes ont incité les chercheurs à utiliser M. smegmatis comme modèle pour les espèces mycobactériennes. Cette espèce partage plus de 2000 gènes homologues avec M. tuberculosis et partage la même structure de paroi cellulaire particulière que M. tuberculosis et d'autres espèces mycobactériennes[3]. Il est également capable d'oxyder le monoxyde de carbone en aérobie, tout comme M. tuberculosis.
La découverte de plasmides, de phages et d'éléments génétiques mobiles a permis la construction de systèmes dédiés d'inactivation de gènes et de rapporteurs de gènes. La souche M. smegmatis mc2155 est hypertransformable et est désormais le cheval de bataille de la génétique mycobactérienne. De plus, il est facilement cultivable dans la plupart des milieux de laboratoire synthétiques ou complexes, où il peut former des colonies visibles en 3 à 5 jours. Ces propriétés en font un organisme modèle très attractif pour M. tuberculosis et d'autres pathogènes mycobactériens. M. smegmatis mc2155 est également utilisé pour la culture de mycobactériophages. Le génome complet de M. smegmatis a été séquencé par TIGR, et des puces à ADN ont été produites par le programme PFGRC (http://pfgrc.tigr.org/descriptionPages.shtml), ajoutant encore à son utilisation comme système modèle pour étudier les mycobactéries.
Transformation
La transformation est un processus par lequel une cellule bactérienne absorbe l'ADN qui avait été libéré par une autre cellule dans le milieu environnant, puis incorpore cet ADN dans son propre génome par recombinaison homologue (voir Transformation (génétique)). Ce sont les souches de M. smegmatis qui ont des machineries de réparation de l'ADN particulièrement efficaces, comme l'indique leur plus grande résistance aux effets néfastes de l'ADN d'agents tels que les UV et la mitomycine C, qui se sont révélées être les plus capables de subir une transformation[4]. Cela suggère que la transformation de M. smegmatis est un processus de réparation de l'ADN, vraisemblablement un processus de réparation recombinant, comme c'est le cas pour d'autres espèces bactériennes[5].
Conjugaison
Le transfert d'ADN conjugal chez M. smegmatis nécessite un contact stable et prolongé entre un donneur et une souche receveuse, est résistant à la DNase et l'ADN transféré est incorporé dans le chromosome du receveur par recombinaison homologue. Cependant, contrairement au système de conjugaison bien connu de E. coli Hfr, chez M. smegmatis, toutes les régions du chromosome sont transférées avec des efficacités comparables et la conjugaison mycobactérienne est chromosomique plutôt que plasmidique. Gray et al.[6] rapportèrent un mélange substantiel des génomes parentaux résultant de la conjugaison et ont fait référence à ce mélange comme rappelant celui observé dans les produits méiotiques de la reproduction sexuelle (voir Origine de la reproduction sexuelle).
Réparation d'ADN
M. smegmatis s'appuie sur les voies de réparation de l'ADN pour résister aux dommages de l'ADN. Les ruptures double brin menacent particulièrement la viabilité bactérienne. M. smegmatis a trois options pour réparer les ruptures double brin : recombinaison homologue (RH), jonction d'extrémité non homologue (NHEJ) et l'annelage brin-unique (SSA, de l'anglais : single-strand annealing)[7]. La voie RH de M. smegmatis est le principal déterminant de la résistance aux rayonnements ionisants et aux dommages oxydatifs à l'ADN. Cette voie implique un échange d'informations entre un chromosome endommagé et un autre chromosome homologue dans la même cellule. Cela dépend de la protéine RecA qui catalyse l'échange de brins et de la protéine ADN qui agit comme une nucléase présynaptique. La recombinaison homologue (RH) est un processus de réparation précis, c'est la voie privilégiée au cours d'une croissance logarithmique[8].
La voie NHEJ pour réparer les ruptures à double brin implique la jonction des extrémités cassées. Il ne dépend pas d'un second chromosome homologue. Cette voie nécessite la protéine Ku et une ADN ligase poly-fonctionnelle ATP-dépendante spécialisée (ligase D)[9]. NHEJ est efficace mais inexacte. La ligature d'extrémités franches d'ADN dans une séquence de gène fonctionnelle se produit avec une fréquence de mutation d'environ 50 %. Le NHEJ est la voie privilégiée en phase stationnaire et protège M. smegmatis contre les effets nocifs de la dessiccation[8].
Le mécanisme SSA (single-strand annealing) est utilisé comme voie de réparation lorsqu'une rupture double brin survient entre des séquences de répétition directes dans l'ADN. Le SSA implique la résection simple brin, la fixation par annelage des répétitions, l'élimination des lambeaux, le remplissage des espaces et la ligature. Chez M. smegmatis, la voie SSA dépend de l'hélicase-nucléase RecBCD[7].
Notes et références
- (en) Cet article est partiellement ou en totalité issu de l’article de Wikipédia en anglais intitulé « Mycobacterium smegmatis » (voir la liste des auteurs).
- ↑ (en) Gordon et Smith, MM, « Rapidly growing, acid fast bacteria. I. Species' descriptions of Mycobacterium phlei Lehmann and Neumann and Mycobacterium smegmatis (Trevisan) Lehmann and Neumann », Journal of Bacteriology, vol. 66, no 1, , p. 41–8 (PMID 13069464, PMCID 357089)
- ↑ (en) Reyrat et Kahn, Daniel, « Mycobacterium smegmatis: an absurd model for tuberculosis? », Trends in Microbiology, vol. 9, no 10, , p. 472–473 (PMID 11597444, DOI 10.1016/S0966-842X(01)02168-0)
- ↑ (en) King, « Uptake of carbon monoxide and hydrogen at environmentally relevant concentrations by mycobacteria », Applied and Environmental Microbiology, vol. 69, no 12, , p. 7266–7272 (PMID 14660375, PMCID PMC310020, DOI 10.1128/aem.69.12.7266-7272.2003)
- ↑ (en) Norgard MV, Imaeda T, « Physiological factors involved in the transformation of Mycobacterium smegmatis », J. Bacteriol., vol. 133, no 3, , p. 1254-62. (PMID 641008, PMCID PMC222159)
- ↑ (en) Michod RE, Bernstein H, Nedelcu AM, « Adaptive value of sex in microbial pathogens », Infect. Genet. Evol., vol. 8, no 3, , p. 267-85. (PMID 18295550, DOI 10.1016/j.meegid.2008.01.002)
- ↑ (en) Gray TA, Krywy JA, Harold J, Palumbo MJ, Derbyshire KM, « Distributive conjugal transfer in mycobacteria generates progeny with meiotic-like genome-wide mosaicism, allowing mapping of a mating identity locus », PLoS Biol., vol. 11, no 7, , e1001602. (PMID 23874149, PMCID PMC3706393, DOI 10.1371/journal.pbio.1001602)
- 1 2 (en) Gupta R, Barkan D, Redelman-Sidi G, Shuman S, Glickman MS, « Mycobacteria exploit three genetically distinct DNA double-strand break repair pathways », Mol. Microbiol., vol. 79, no 2, , p. 316-30. (PMID 21219454, PMCID PMC3812669, DOI 10.1111/j.1365-2958.2010.07463.x)
- 1 2 (en) Pitcher RS, Green AJ, Brzostek A, Korycka-Machala M, Dziadek J, Doherty AJ, « NHEJ protects mycobacteria in stationary phase against the harmful effects of desiccation », DNA Repair (Amst.), vol. 6, no 9, , p. 1271-6. (PMID 17360246, DOI 10.1016/j.dnarep.2007.02.009, lire en ligne [PDF])
- ↑ (en) Gong C, Bongiorno P, Martins A, Stephanou NC, Zhu H, Shuman S, Glickman MS, « Mechanism of nonhomologous end-joining in mycobacteria: a low-fidelity repair system driven by Ku, ligase D and ligase C », Nat. Struct. Mol. Biol., vol. 12, no 4, , p. 304-12. (PMID 15778718, DOI 10.1038/nsmb915)
- Portail de la microbiologie
- Portail de la biologie cellulaire et moléculaire